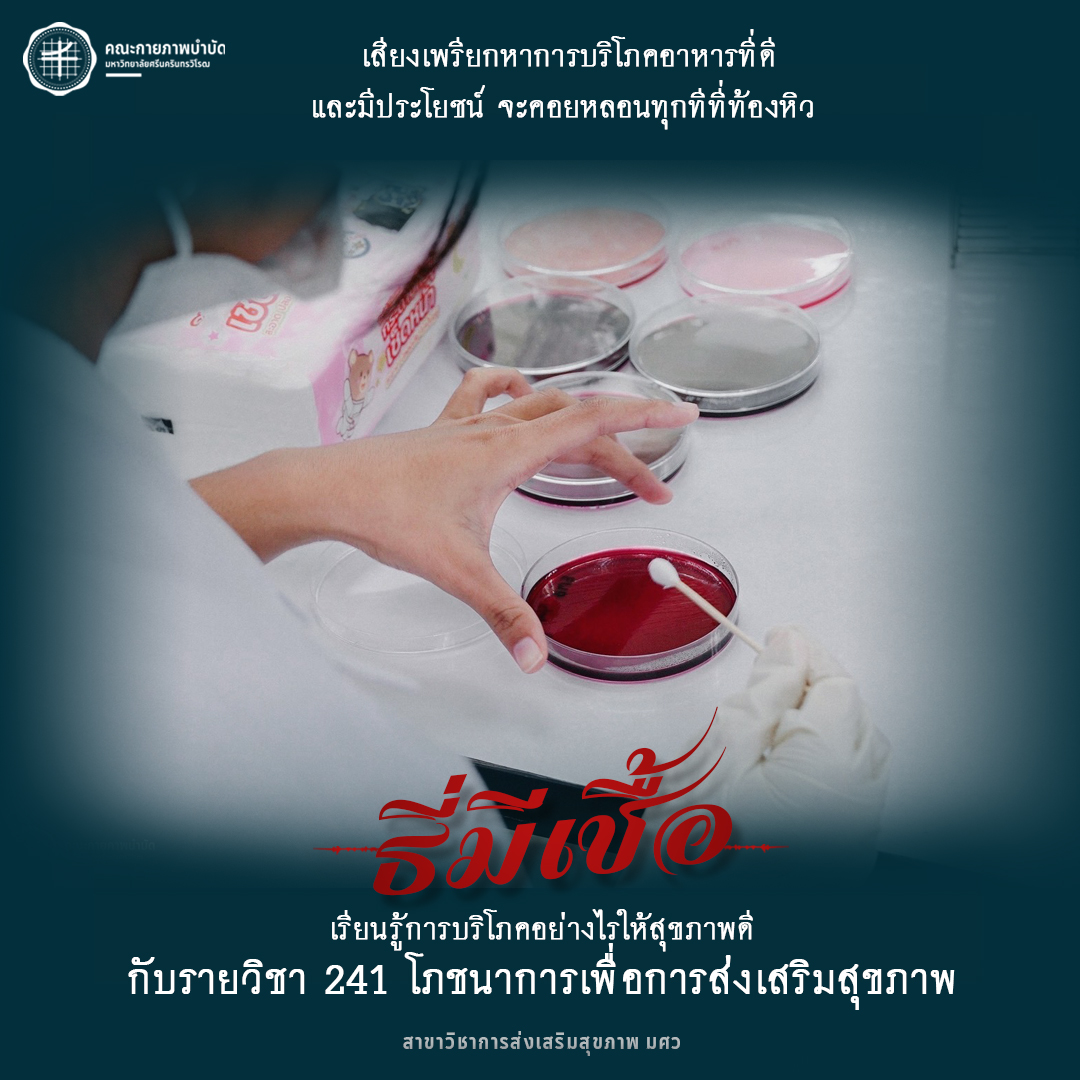

ข่าวประชาสัมพันธ์
กลับมาหลอนกันอีกครั้งกับ ธี่ไหนจะหลอนเท่า..."ธี่แคส (TCAS)"
เสียงเพรียกแห่งอนาคต ที่จะคอยหลอนน้อง ๆ ม.6 ว่า...
"ทำพอร์ตหรือยัง!?"
TCAS ปีการศึกษา 2568 รอบที่ 1 Portfolio
เตรียมตัวให้ดี ปีนี้รับเยอะ!!
คณะกายภาพบำบัด มศว
เสียงเพรียกแห่งอนาคตของสังคมสุขภาพดี ที่จะคอยหลอนให้ทุกคนตระหนักถึงการส่งเสริมสุขภาพ มาร่วมเป็นส่วนหนึ่งของการสร้างสังคมสุขภาพดีไปด้วยกัน กับสาขาการส่งเสริมสุขภาพ มศว
พบกับรายวิชา "ธี่"น่าสนใจ
เตรียมตัวให้พร้อม เปิดรับสมัครวันที่ 12 พฤศจิกายน – 9 ธันวาคม 2567
(ส่งแฟ้มสะสมผลงานในรูปแบบของไฟล์ PDF เท่านั้น)
ติดตามรายละเอียดการรับสมัครเพิ่มเติมได้ที่นี่ เร็ว ๆ นี้
วันเริ่ม